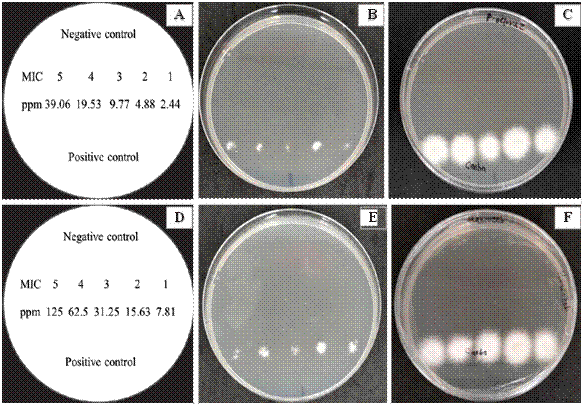
Fungicidal effect of Prochloraz and Mancozeb on the spore solution of Fusarium solani obtained from the microdilution plate after two days of evaluation. A) Distribution in Petri dishes with PDA medium of five MIC obtained from Prochloraz, B and C) No mycelial growth of F. solani in the MIC of Prochloraz evaluated after 24 and 48 h, D) Distribution in Petri dishes with PDA medium of five MIC obtained from Mancozeb, E and F) No mycelial growth of F. solani in the MIC of Mancozeb evaluated after 24 and 48 h.

Artículos Científicos
Fusarium solani associated with Cedrela odorata and Swietenia macrophylla and their sensitivity to conventional fungicides
-
Publication dates-
May 27, 2025
Sep-Dec , 2024
- Article in PDF
- Article in XML
- Automatic translation
- Send this article by e-mail
- Share this article +
ABSTRACT
Background
/ Objective. In the state of Yucatan, Mexico, 10 million forest plants were produced in the last five years for various conservation and restoration actions. The main limitations in the production of these plants in nursery are disease induced by the genus Fusarium spp., that cause stem and root rots and plant production losses of up to 50%. The objective of the work was to identify the causal agent associated with stem and root rot and necrosis of cedar (Cedrela odorata) and mahogany (Swietenia macrophylla) and their in vitro sensitivity to conventional fungicides.
Materials and Methods.
C. odorata and S. macrophylla plants were collected at three and six weeks of germination, respectively, with symptoms of necrosis and rot indicated; from where five fungal isolates were obtained and morphologically and molecularly identified. The Minimum Inhibitory Concentration (MIC) of spores and the Minimum Lethal Concentration (MLC) of six conventional fungicides of recurrent application in the region (Prochloraz, Carbendazim, Benomyl, Fosetyl Al, Captan and Mancozeb) were determined in vitro by the microdilution method and validate their effectiveness and viability in the management of this problematic.
Results.
The morphology and molecular sequences of the isolates were similar to the reported for Fusarium solani. The MIC of F. solani spores for Prochloraz, Carbendazim, Benomyl, Captan and Mancozeb were 2.44. 11.38, 14.06, 7.81 and 7.81 ppm, respectively; Fosetyl Al, did not inhibit spore germination normal
mycelial growth of the fungus was observed at the concentration evaluated.
Conclusion.
Prochloraz and Mancozeb had the lowest MLC with 2.44 and 7.81 ppm, respectively.
Key words::
cedar, mahogany, root of rot, nursery, chemical control
Introduction
In Mexico, approximately 1 billion forest plants were produced over the last five years, including species from arid, temperate, and tropical climates. Of this production, the state of Yucatán produced around 10 million plants for various reforestation or restoration efforts. The main species produced were C. odorata, S. macrophylla, Tabebuia rosea, Brosimun alicastrum, and Cordia dodecandra (SNIGF, 2021). One of the limiting factors in the production process is stem and root rot diseases caused by Fusarium spp. (Kisekka, 2022). According to information provided by nursery growers, production losses range from 30 to 50%.
-
Kisekka, 2022Major diseases of nursery forestry tree seedlings in UgandaNational Agricultural Research Organization, 2022
The genus Fusarium has approximately 1,779 species with a cosmopolitan distribution (Sun et al., 2023). They are ubiquitous in nature, as they can tolerate any environmental condition. They can be found in air, water, soil, plants, and plant debris. A large number of its species are plant pathogens, producers of mycotoxins, and induce a wide range of diseases that affect various crops. The symptoms they cause mainly include root and stem rot, cankers, vascular wilt, and fruit and seed rot (Ekwomadu and Mwanza, 2023).
-
Sun et al., 2023Diversity and pathogenic characteristics of the Fusarium species isolated from minor legumes in KoreaNature Portfolio, 2023
-
Ekwomadu and Mwanza, 2023Fusarium Fungi Pathogens, Identification, Adverse Effects, Disease Management, and Global Food Security: A Review of the Latest ResearchAgriculture, 2023
In nurseries of temperate regions, characterized by a humid or subhumid climate with average temperatures between 12 and 18 °C and annual precipitation between 600 and 1500 mm (GeoEnciclopedia, 2022), the vegetation consists of pine forests, oak forests, and pine-oak forests (Galicia et al., 2018). In this context, F. circinatum in pine plants causes the main disease known as “pitch canker,” characterized by root rot, reducing plant quality and leading to production losses of up to 40% (García-Díaz et al., 2017). In tropical regions, where the temperature is above 18 °C and annual precipitation ranges from 800 to 4000 mm (GeoEnciclopedia, 2022), and the vegetation consists of various species of evergreen, sub-evergreen, deciduous, and sub-deciduous types (Secretaría de Medio Ambiente y Recursos Naturales, 2017), Fusarium sp. has been identified as responsible for stem rot in Eucalyptus pellita (Arsensi and Mardji, 2021) and F. solani as the causal agent of root rot in Tectona grandis (Kiran et al., 2021).
-
Galicia et al., 2018Perspectivas del enfoque socioecológico en la conservación, el aprovechamiento y pago de servicios ambientales de los bosques templados de MéxicoMadera y Bosques, 2018
-
García-Díaz et al., 2017Efecto de Fusarium circinatum en la germinación y crecimiento de plántulas de Pinus greggii en tres sustratosAgrociencia, 2017
-
Arsensi and Mardji, 2021Diseases of Shoot, Stem and Root on Eucalyptus pellita F. Muell. At Sebulu, East KalimantanAdvances in Biological Sciences Research, 2021
-
Kiran et al., 2021Documentation and characterization of fungal diseases in nursery seedlings of teak (Tectona grandis L.f.) in Kerala, IndiaIndian Phytopathology, 2021
In Mexico, information on the diagnosis and etiology of the causal agents of fungal diseases observed in tropical forest nurseries is scarce, as well as on the methods used for their control. Currently, the control of these diseases in forest plants growing in nurseries relies on synthetic fungicides due to their rapid response in controlling the pathogen and their ease of application (Kisekka, 2022). However, applications are sometimes unsuccessful because no prior sensitivity studies are conducted in vitro and in vivo with the available local fungicides.
-
Kisekka, 2022Major diseases of nursery forestry tree seedlings in UgandaNational Agricultural Research Organization, 2022
In plant production in nurseries, good phytosanitary conditions are the foundation of any production or reforestation project, as planting diseased plants in the field lowers their chances of survival and makes them sources of inoculum for healthy plants. To develop an effective control method for the phytosanitary problems affecting nursery plants, identifying the causal agents is essential. This knowledge allows for the design of efficient control strategies and the application of specific products for their management, thereby also reducing environmental contamination. Thus, the objective of this work was to identify the causal agent associated with stem and root rot and necrosis of C. odorata and S. macrophylla and its in vitro sensitivity to conventional fungicides.
Materials and Methods
Sample collection. In 2023, at the Mexico Primero nursery located at 88° 58´48.15¨ W and 19° 59´10.56¨ N, in the municipality of Tzucacab, Yucatan, plants of C. odorata and S. macrophylla were collected at three- and six-weeks post- germination, respectively, showing symptoms of stem and root base necrosis and rot (Figure 1). Samples were placed in brown paper bags, then transferred to plastic bags, labeled, and transported to the Phytopathology Laboratory of the National Technological Institute of Mexico, Campus Conkal, for isolation and identification of the causal agent(s).
Isolates from Symptoms. The stems and roots of plants showing symptoms of necrosis and rot were rinsed with tap water to remove substrate residues. Approximately 0.5 to 1 cm² cuts were made from the damaged tissue. To eliminate external contaminants, they were disinfested with 2% commercial sodium hypochlorite for 2 minutes. Subsequently, they were rinsed three times with sterile distilled water for 2 minutes each and dried with sterile absorbent paper. Finally, five fragments of approximately 0.5 to 1 cm² were placed in Petri dishes with Potato Dextrose Agar (PDA) medium and incubated at 28±2 °C. After 48 hours, mycelial growth was observed and re-isolated onto PDA culture plates. The re- isolated mycelial growths were purified using hyphal tips and subsequently from spores, monosporic cultures were initiated (Ríos-Hernández et al., 2021), yielding three isolates of C. odorata and two isolates of S. macrophylla.
-
Ríos-Hernández et al., 2021Control biológico de Fusarium oxysporum, agente causal de la pudrición del cormo en gladiolo, mediante estreptomicetosRevista Mexicana de Fitopatología, 2021
Thumbnail
Figure 1
Plants with symptoms of necrosis and rot in the stem and root. A, B, and C) Cedrela odorata plants. D, E, and F) Swietenia macrophylla plants.
Plants with symptoms of necrosis and rot in the stem and root. A, B, and C) Cedrela odorata plants. D, E, and F) Swietenia macrophylla plants.
Morphological identification. For the morphological identification of fungal isolates at the genus level, sterile samples of approximately 5 mm diameter mycelium were taken with a dissecting needle. These were placed in Petri dishes with PDA medium and incubated at 28±2 °C. They were monitored until reproductive structures appeared, assessing growth characteristics such as mycelial type, isolate color, type and shape of spores, and fruiting bodies (Barnett and Hunter 1998; Leslie et al., 2006). Semi-permanent preparations were made and morphological features were observed under a microscope (Axiostar Plus, Carl Zeiss) equipped with an ocular measurement grid, calibrated for each objective as necessary. Length and width measurements (n=100) of macroconidia and microconidia were taken.
-
Barnett and Hunter 1998Illustrated Genera of Imperfect Fungi, 1998
-
Leslie et al., 2006The Fusarium laboratory manual, 2006
Molecular identification. Considering that the five isolates exhibited similar morphological characteristics, one isolate from each host was randomly selected for molecular identification. This involved DNA extraction from each fungus using the DNeasy Kit (QIAGEN). The extracted DNA was used to amplify the Internal Transcribed Spacer (ITS) region through Polymerase Chain Reaction (PCR), employing the universal primers ITS4 (5’-TCCTCCGCTTATTGATATGC-3’) and ITS5 (5’-GGAAGTAAAAGTCGTAACAAGG-3’) (White et al., 1990), and
-
White et al., 1990Amplification phylogeneticsPCR Protocols: A guide to methods and applications, 1990
elongation factor-1α with primers EF-1 (5′-ATGGGTAAGGARGACAAGAC-3′) and EF-2 (5′-GGARGTACCAGTSATCATG¬TT-3′) (Ríos-Hernández et al., 2021). PCR amplification conditions were as follows: Initial denaturation at 94
-
Ríos-Hernández et al., 2021Control biológico de Fusarium oxysporum, agente causal de la pudrición del cormo en gladiolo, mediante estreptomicetosRevista Mexicana de Fitopatología, 2021
°C for 30 s, followed by 38 cycles (denaturation at 90 °C for 30 s, annealing at 58 °C for 45 s, and extension at 72 °C for 1 min), with a final extension at 72 °C for 5 min (Uc-Várguez et al., 2018). Amplification was conducted using an AB thermocycler (Applied Biosystems), and the PCR products were analyzed by 1% agarose gel electrophoresis. Purification and sequencing of the PCR products were performed at Macrogen Genome Center in Seoul, Republic of Korea. The resulting sequences were edited using BioEdit software (version 7.7.1, available online) and subsequently compared with sequences in the National Center for Biotechnology Information (NCBI, 2024) database using the BLAST tool, also available online.
-
Uc-Várguez et al., 2018Spatio-temporal spread of foot rot (Lasiodiplodia theobromae) in Jatropha curcas L. plantations in Yucatán, MéxicoEuropean Journal of Plant Pathology, 2018
Minimum Inhibitory Concentration for Spore Germination and Minimum Lethal Concentration. To estimate the antifungal activity of six active ingredients from conventional fungicides (Table 1) against fungal isolates of C. odorata and S. macrophylla, the Minimum Inhibitory Concentration (MIC) for spore germination was determined. The microdilution method was used in sterile 96-well polystyrene microplates with Potato Dextrose Agar at twice its concentration (CLSI, 2017; CLSI, 2020). Each well of the microplate received 100 μL of Potato Dextrose broth, and 100 μL of sterile distilled water was added to wells in the negative control row. Subsequently, each well in the first column received 100 μL of the respective fungicidal solution, mixed thoroughly. 100 μL of the mixture from each well was transferred to the wells of the second column, and so forth, maintaining a 50% concentration of the fungicidal solution from the first well onwards. After dilutions
Table 1
Conventional fungicides evaluated for their effect on spore germination and mycelial growth of Fusarium solani isolated from Cedrela odorata and Swietenia macrophylla.
Conventional fungicides evaluated for their effect on spore germination and mycelial growth of Fusarium solani isolated from Cedrela odorata and Swietenia macrophylla.
| Fungicide (a. i.) | Fungicide group | Type of fungicide | Maximum initial dose (ppm) |
|---|---|---|---|
| Prochloraz | Imidazole | Systemic | 625 |
| Carbendazim | Bencimidazole | Systemic | 364 |
| Benomyl | Bencimidazole | Systemic | 225 |
| Fosetyl Al | Ethyl phosphonate | Systemic | 1500 |
| Captan | Phthalimide | Contact | 1000 |
| Mancozeb | Ditihocarbamate | Contact | 1000 |
were complete, 100 μL of spores of the fungus, counted in a Neubauer chamber at a concentration of 1 x 105 spores mL-1, were added to each well. Positive control wells contained Potato Dextrose broth and fungus spores at described concentrations, resulting in a final volume of 200 μL per well. The contents of each well were mixed (Harčárová et al., 2021; Ríos-Hernández et al., 2021). Microplates were incubated at 29°C; the assay followed a completely randomized experimental design with four replicates. Data were analyzed using analysis of variance after data transformation with SAS ver. 9.4 (y=arsin(sqrt(y/100)), and mean comparisons were performed using Tukey’s method (p≤0.05). Spore germination inhibition was evaluated at 24, 48, and 72 hours using resazurin (Sharma et al., 2016; Balouri et al., 2016; Kumar et al., 2016; Ríos-Hernández et al., 2021) as an oxidation-reduction indicator to confirm spore viability by a change from blue (non-fluorescent) to pink-red (fluorescent) staining due to chemical reduction of the growth medium by microbial cell growth (Elshikh et al., 2016; Caso et al., 2021). The MIC of each fungicide, defined as the lowest concentration preventing fungal mycelial growth, was determined after two hours of incubation (Kowalska-Krochmal and Dudek- Wicher, 2021). Subsequently, the Minimum Lethal Concentration (MLC), defined as the lowest concentration of fungicide at which no fungal growth was observed 24 hours after subculturing in fungicide-free medium (Perczak et al., 2019; Harčárová et al., 2021; Ríos-Hernández et al., 2021), was calculated in triplicate using 5 μL of fungal content inhibited at the MIC and four concentrations above the MIC, incubated at 29 °C. Fungal growth presence or absence was observed at 24 hours; fungistatic activity was noted when fungal growth occurred, and fungicidal activity when no growth was observed (Ríos-Hernández et al., 2021).
-
Harčárová et al., 2021Comparison of antifungal activity of selected essential oils against Fusarium graminearum in vitroAnnals of Agricultural and Environmental Medicine, 2021
-
Ríos-Hernández et al., 2021Control biológico de Fusarium oxysporum, agente causal de la pudrición del cormo en gladiolo, mediante estreptomicetosRevista Mexicana de Fitopatología, 2021
-
Sharma et al., 2016Antifungal activities of selected essential oils against Fusarium oxysporum f. sp. lycopersici, with emphasis on Syzygium aromaticum essential oilJournal of Bioscience and Bioengineering, 2016
-
Balouri et al., 2016Methods for in vitro evaluating antimicrobial activity: A reviewJournal of Pharmaceutical Analysis, 2016
-
Kumar et al., 2016Antifungal efficacy of plant essential oils against stored grain fungi of Fusarium spp.Journal of Food Science and Technology, 2016
-
Elshikh et al., 2016Resazurin-based 96-well plate microdilution method for the determination of minimum inhibitory concentration of biosurfactantsBiotechnol Lett, 2016
-
Caso et al., 2021Evaluation of antimicrobial susceptibility testing of Nocardia spp. isolates by broth microdilution with resazurin and spectrophotometryBMC Microbiology, 2021
-
Kowalska-Krochmal and Dudek- Wicher, 2021Inhibitory Concentration of Antibiotics: Methods, Interpretation, Clinical RelevancePathogens, 2021
-
Perczak et al., 2019Antifungal activity of selected essential oils against Fusarium culmorum and F. graminearum and their secondary metabolites in wheat seedsArchives of Microbiology, 2019
Results and Discussion
Morphological identification. The morphological characteristics of the five isolates from necrosis, stem rot, and root rot of C. odorata and S. macrophylla (Figure 2) exhibited septate and smooth mycelium during the first four to five days of growth, becoming cottony with shades ranging from white to pale cream by day
8. Abundant microconidia were produced in long monophialides, hyaline, oval, and fusiform, generally with zero to one septum, measuring 8-25 μm long and 3.5-5 μm wide; irregularly shaped sporodochia of pale cream color and numerous robust, slightly curved, hyaline macroconidia with three to four septa, measuring 24-36 μm long and 4-5 μm wide were observed. Single and double chlamydospores with a globular shape and thick walls were also noted. These isolate characteristics were consistent with those described for Fusarium solani (Leslie et al., 2006; Hafizi et al., 2013; Omar et al., 2018; Kurt et al., 2020).
-
Leslie et al., 2006The Fusarium laboratory manual, 2006
-
Hafizi et al., 2013Morphological and molecular characterization of Fusarium solani and F. oxysporum associated with crown disease of oil palmBrazilian Journal of Microbiology, 2013
-
Omar et al., 2018Characterization and pathogenicity of Fusarium species associated with leaf spot of mango (Mangifera indica L.)Microbial Pathogenesis, 2018
-
Kurt et al., 2020Characterization and pathogenicity of Fusarium solani associated with dry root rot of citrus in the eastern Mediterranean region of TurkeyJournal of General Plant Pathology, 2020
Thumbnail
Figure 2
A and D) View of 14-day-old Fusarium solani isolated from Cedrela odorata and Swietenia macrophylla, B) Septate mycelium and microconidia of F. solani, C) Macroconidia (3-4 septa) and microconidia (0-1 septum) of F. solani observed at 100X magnification, E) Macroconidia and microconidia observed at 40X magnification, and F) Sporodochia.
A and D) View of 14-day-old Fusarium solani isolated from Cedrela odorata and Swietenia macrophylla, B) Septate mycelium and microconidia of F. solani, C) Macroconidia (3-4 septa) and microconidia (0-1 septum) of F. solani observed at 100X magnification, E) Macroconidia and microconidia observed at 40X magnification, and F) Sporodochia.
Molecular identification. The resulting sequences from the amplified fragments of the ITS region (600 bp) of the two isolates from C. odorata and S. macrophylla, when compared to sequences in the NCBI database, showed similarities of 99.26% and 99.79%, respectively, with sequences corresponding to F. solani and F. falciforme. Consequently, analysis of the sequences from the fragments of the elongation factor-1α (700 bp) genes of the same isolates revealed similarities of 99.83% and 95.73%, respectively, with sequences of F. solani and F. falciforme. Considering the morphological characteristics and close molecular similarity of the analyzed sequences, it is concluded that the two isolates from necrosis, stem rot, and root rot of C. odorata and S. macrophylla correspond to F. solani, given that
F. falciforme is a member of the F. solani complex, which encompasses a diversity of genotypes due to its genetic variability and ecological plasticity (Sabahi et al., 2023). This constitutes the first report of F. solani associated with nursery plant production in C. odorata and S. macrophylla in southeastern Mexico.
-
Sabahi et al., 2023Molecular Variability of the Fusarium solani Species Complex Associated with Fusarium Wilt of Melon in IranJournal of Fungi, 2023
Determination of MIC and MLC of synthetic fungicides against F. solani. Prochloraz inhibited spore germination and consequently the growth of F. solani at concentrations starting from 2.44 ppm and higher. Treated spores exhibited a blue (non-fluorescent) staining compared to the positive control spores, which changed from blue to pink-red (fluorescent), indicating fungal cell growth. Upon determining the MLC, the fungicidal effect persisted, with fungal samples from spores treated with fungicide concentrations subcultured in fungicide-free PDA medium showing no mycelial growth during the 24-hour evaluation, unlike fungal samples from the positive control that did develop mycelial growth (Figure 3). Based on these results, 2.44 ppm was both the MIC and MLC of Prochloraz (Table 2). This demonstrates that Prochloraz caused spore death by preventing germination and mycelial growth. These findings directly correlate with the fungicide’s mode of action, which disrupts sterol biosynthesis (Medina-Osti et al., 2022), particularly targeting ergosterol, an essential component of the fungal plasma membrane that maintains rigidity and permeability of spores. Disruption of this component can lead to membrane structure lysis, affecting nutrient transport and chitin synthesis, both crucial for mycelial growth. Studies on F. oxysporum and Colletotrichum acutatum showed structural damage, resulting in shrunken and wrinkled spores, and consequently fungal inviability, upon ergosterol inhibition (Kim et al., 2019). Similar effectiveness was observed in other studies where concentrations of 4, 40, and 400 ppm of Prochloraz inhibited the growth of F. graminearum, F. proliferatum, and F. verticillioides, causing corn ear rot (Massiello et al., 2019), and in Fusarium sp. causing citrus vascular wilt, with 100 ppm inhibiting mycelial growth by 92% (Ortiz-Martínez et al., 2022).
-
Medina-Osti et al., 2022In vitro sensitivity of Fusarium sacchari isolated from sugar cane to five fungicidesMexican Journal of Phytopathology, 2022
-
Kim et al., 2019Antifungal Activities of Streptomyces blastmyceticus Strain 12-6 Against Plant Pathogenic FungiMycobiology, 2019
-
Ortiz-Martínez et al., 2022Fusarium sp., causal agent of vascular wilt in citrus and its sensitivity to fungicidesMexican Journal of Phytopathology, 2022
Thumbnail
Figure 3
Fungicidal effect of Prochloraz and Mancozeb on the spore solution of Fusarium solani obtained from the microdilution plate after two days of evaluation. A) Distribution in Petri dishes with PDA medium of five MIC obtained from Prochloraz, B and C) No mycelial growth of F. solani in the MIC of Prochloraz evaluated after 24 and 48 h, D) Distribution in Petri dishes with PDA medium of five MIC obtained from Mancozeb, E and F) No mycelial growth of F. solani in the MIC of Mancozeb evaluated after 24 and 48 h.
Fungicidal effect of Prochloraz and Mancozeb on the spore solution of Fusarium solani obtained from the microdilution plate after two days of evaluation. A) Distribution in Petri dishes with PDA medium of five MIC obtained from Prochloraz, B and C) No mycelial growth of F. solani in the MIC of Prochloraz evaluated after 24 and 48 h, D) Distribution in Petri dishes with PDA medium of five MIC obtained from Mancozeb, E and F) No mycelial growth of F. solani in the MIC of Mancozeb evaluated after 24 and 48 h.
Table 2
Minimum inhibitory concentration (MIC) and minimum lethal concentration (MLC) of conventional fungicides against Fusarium solani isolated from Cedrela odorata and Swietenia macrophylla.
Minimum inhibitory concentration (MIC) and minimum lethal concentration (MLC) of conventional fungicides against Fusarium solani isolated from Cedrela odorata and Swietenia macrophylla.
| Fungicide- treatment (a.i.) | MIC (ppm) | y Inhibition of spore germination (%) | MLC (ppm) | z Inhibition of mycelial growth (%) |
|---|---|---|---|---|
| Prochloraz | 2.44 | 100 a | 2.44 | 100 a |
| Carbendazim | 11.38 | 100 a | 11.38 | 0 b |
| Benomyl | 14.06 | 100 a | 14.6 | 0 b |
| Fosetyl-Al | 1500 | 0 b | 1500 | 0 b (-) |
| Captan | 7.81 | 100 a | 7.81 | 0 b |
| Mancozeb | 7.81 | 100 a | 7.81 | 100 a |
| Control | 0 | 0 b | 0 | 0 b (-) |
The MIC assay for Carbendazim started at 11.38 ppm (Table 2). However, when evaluating the fungicide’s effect and estimating the MLC, mycelial growth occurred when subcultured in fungicide-free PDA medium, suggesting a fungistatic rather than fungicidal effect. Different results were observed in isolates from papaya causing root rot, where this fungicide at 150 ppm inhibited mycelial growth by
93.5 to 95.3% (Kumar et al., 2020) and at 750 ppm inhibited 100% of F. solani growth causing tomato vascular wilt (Ayvar-Serna et al., 2021). For Benomyl, the MIC was 14.06 ppm (Table 2), inhibiting spore germination of F. solani. However, like Carbendazim, when evaluating the MLC, spores regained viability, showing mycelial growth, also suggesting a fungistatic effect at these doses. In studies with doses higher than 250 ppm, it inhibited 100% mycelial growth (Coronel et al., 2022). But in F. oxysporum, responsible for strawberry plant wilt and collapse, mycelial growth was inhibited at concentrations as low as 5 ppm (Vega-López and
-
Kumar et al., 2020In vitro efficacy of different fungicides against Fusarium solani isolate causing root rot of papaya (Carica papaya L.)International Journal of Chemical Studies, 2020
-
Ayvar-Serna et al., 2021Actividad antifúngica de pesticidas biológicos, botánicos y químicos sobre el agente causal de la marchitez vascular del jitomateRevista Fitotecnia Mexicana, 2021
-
Coronel et al., 2022Efficacy of four in vitro fungicides for control of wilting of strawberry crops in Puebla-MexicoApplied Sciences, 2022
Granado-Montero, 2023). These findings suggest that fungicide effectiveness also depends on the species and strain of the phytopathogen. Carbendazim and Benomyl, classified as preventive and curative, inhibit motor proteins and the cytoskeleton, specifically in the assembly of β-tubulin during mitosis, affecting cell division, movement, appressorium formation, and overall mycelial growth (Alburqueque and Gusqui, 2018; FRAC, 2024). Conversely, none of the evaluated concentrations of Fosetyl-Al showed antifungal activity, as fungal growth occurred, confirming the low effectiveness and selectivity of this active ingredient with oomicide effect (Cristóbal-Alejo et al., 2013). Although there are few cases of resistance in some phytopathogens, frequent use may reduce its effectiveness in controlling fungal phytopathogens (FRAC, 2024).
-
Alburqueque and Gusqui, 2018Eficacia de fungicidas químicos para el control in vitro de diferentes fitopatógenos en condiciones controladasArnaldoa, 2018
-
Cristóbal-Alejo et al., 2013Hifomicetos asociados a plantas tropicales del estado de Yucatán, México: Identificación genérica y evaluación de fungicidas para su controlRevista Protección Vegetal, 2013
For Captan and Mancozeb, the MIC was 7.81 ppm (Table 2). At this concentration, spore germination of the fungus was inhibited up to the higher evaluated concentrations, as indicated by no change in resazurin staining in the microplates compared to the positive controls, where resazurin staining did change. However, in the assay to determine the fungicide’s effect and the MLC, only Mancozeb at this concentration showed an MLC effect on F. solani. There was no mycelial growth of the fungus at this and higher evaluated concentrations when subcultured in fungicide-free PDA medium from the microplates containing fungicide concentrations (Figure 2). This indicated that Mancozeb not only inhibited spore germination while in contact but also caused spore death, preventing mycelial development.
In contrast, Captan allowed mycelial growth similar to the positive control, suggesting it only prevented spore germination while in contact in the microplates. These results suggest that although both fungicides are contact fungicides with multi-site action affecting spore germination (FRAC, 2024), concentration and exposure time might influence effectiveness. The 48-hour contact period with Captan was insufficient for cell penetration. Recent evaluations showed efficacy against Fusarium species. When tested against F. incarnatum, a fungus associated with grass seed damage, Captan and Mancozeb at concentrations of 200 and 300 ppm inhibited mycelial growth by 97.8% and 93%, respectively (Zárate-Ramos et al., 2021). Against F. falciforme, recently identified as a root and stem pathogen of soursop, concentrations of 12,500 and 10,000 ppm inhibited fungal growth by 95 to 100% (Cambero-Ayón et al., 2023). Additionally, Captan interferes with the fungal respiration mechanism, hindering germination and mycelial development, while Mancozeb modifies and inactivates redox-sensitive proteins involved in transcription, translation, and oxidative DNA stress (Zárate-Ramos et al., 2021) Finally, only Prochloraz and Mancozeb showed fungicidal effects, with no mycelial growth of F. solani observed during the MLC assay after 24 and 48 hours of subculturing in fungicide-free PDA medium, confirming spore death. In contrast,
-
Cambero-Ayón et al., 2023Supresión in vitro de patógenos fúngicos de raíz en Annona muricata L. por cepas de Trichoderma y fungicidas convencionalesRevista Bio Ciencias, 2023
Carbendazim, Benomyl, and Captan exhibited fungistatic effects, as mycelial growth occurred during the MLC test after 24 and 48 hours of exposure in PDA medium without fungicide. This indicated that these fungicides did not kill the spores but only inhibited germination while in contact, with viability and growth resuming once removed from the fungicide medium (Table 2 and Figure 3).
Conclusions
The morphotaxonomic characteristics and molecular sequence analysis of the isolates from stem and root necrosis and rots of C. odorata and S. macrophylla corresponded to F. solani. This species was thus associated as the probable biotic factor responsible for 30 to 50% of the estimated plant production losses by nurserymen in southeastern Mexico.
Prochloraz and Mancozeb showed the best in vitro antifungal effects against F. solani, with average MIC and MLC values of 2.44 and 7.81 ppm, respectively.
Literatura Citada
- Alburqueque, AD, Gusqui, MR (2018). Eficacia de fungicidas químicos para el control in vitro de diferentes fitopatógenos en condiciones controladas. Arnaldoa, 25(2), 489-498. 10.22497/arnaldoa.252.25209. Links
- Arsensi, I, Mardji, D (2021). Diseases of Shoot, Stem and Root on Eucalyptus pellita F. Muell. At Sebulu, East Kalimantan. Advances in Biological Sciences Research, 11, 186-192. 10.2991/absr.k.210408.031. Links
- Ayvar-Serna, S, Díaz-Nájera, JF, Vargas-Hernández, M, Enciso-Maldonado, GA, Alvarado-Gómez, OG, Ortiz-Martínez, AI (2021). Actividad antifúngica de pesticidas biológicos, botánicos y químicos sobre el agente causal de la marchitez vascular del jitomate. Revista Fitotecnia Mexicana, 44(4), 617-624. 10.35196/rfm.2021.4.617. Links
- Balouri, M, Sadiki, M, Koraichi, IS (2016). Methods for in vitro evaluating antimicrobial activity: A review. Journal of Pharmaceutical Analysis, 6, 71-79. 10.1016/j.jpha.2015.11.005. Links
- Barnett, HL, Hunter, B (1998). Illustrated Genera of Imperfect Fungi, 4th Ed. St. Paul, Minnesota, USA: The American Phytopathological Society. 218 p. https://www.academia.edu/35499449/Illustrated_genera_of_imperfect_fungi_fourth_edition_Barnett_y_Hunter_pdf_pdf. Links
- Cambero-Ayón, CB, Rios-Velasco, C, Luna-Esquivel, G, López-Guzmán, GG, Estrada-Virgen, MO, Cambero-Campos, OJ (2023). Supresión in vitro de patógenos fúngicos de raíz en Annona muricata L. por cepas de Trichoderma y fungicidas convencionales. Revista Bio Ciencias. 10.15741/revbio.10.e1497. Links
- Caso, CV, Pereira, NSD, Cintra, GM, Benard, G, Lopes, MH, Keiko, SP (2021). Evaluation of antimicrobial susceptibility testing of Nocardia spp. isolates by broth microdilution with resazurin and spectrophotometry. BMC Microbiology, 21, 331-338. 10.1186/s12866-021-02394-w. Links
- CLSI (2017). Performance standards for antimicrobial susceptibility testing. 27th ed. CLSI supplement M100. Wayne, Pennsylvania, USA: Clinical and Laboratory Standards Institute. 282 p. https://goums.ac.ir/files/deputy_treat/md_labs_ef39a/files/M100-S27_CLSI_2017.pdf (consulta, enero 2024). Links
- CLSI (2020). Performance standards for antimicrobial susceptibility testing. 30th ed. CLSI supplement M100. Wayne, Pennsylvania, USA: Clinical and Laboratory Standards Institute. 332 p. https://www.nih.org.pk/wp-content/uploads/2021/02/CLSI-2020.pdf (consulta, febrero 2024). Links
- Coronel, AC, Parraguirre, LC, Pacheco, HY, Santiago, TO, Rivera, TA, Romero, AO (2022). Efficacy of four in vitro fungicides for control of wilting of strawberry crops in Puebla-Mexico. Applied Sciences, 12(3213), 2-15. 10.3390/app12073213. Links
- Cristóbal-Alejo, J, Navarrete-Mapen, Z, Herrera-Parra, E, Mis-Mut, M, Tun-Suárez, JM, Ruiz-Sánchez, E (2013). Hifomicetos asociados a plantas tropicales del estado de Yucatán, México: Identificación genérica y evaluación de fungicidas para su control. Revista Protección Vegetal, 28(2), 138-144. Links
- Ekwomadu, ET, Mwanza, M (2023). Fusarium Fungi Pathogens, Identification, Adverse Effects, Disease Management, and Global Food Security: A Review of the Latest Research. Agriculture, 13(1810), 2-20. 10.3390/agriculture13091810. Links
- Elshikh, M, Ahmed, S, Funston, S, Dunlop, P, McGaw, M, Marchant, R, Banat, IM (2016). Resazurin-based 96-well plate microdilution method for the determination of minimum inhibitory concentration of biosurfactants. Biotechnol Lett, 38, 1015-1019. 10.1007/s10529-016-2079-2. Links
- FRAC (2024). Fungal control agents by cross resistance pattern and mode of action. https://www.frac.info (consulta, marzo 2024). Links
- Galicia, L, Chávez-Vergara, BM, Kolb, M, Jasso-Flores, RI, Rodríguez-Bustos, LA, Solís, LE, Guerra de la Cruz, V, Pérez-Campuzano, E, Villanueva, A (2018). Perspectivas del enfoque socioecológico en la conservación, el aprovechamiento y pago de servicios ambientales de los bosques templados de México. Madera y Bosques, 4(2), 1-18. 10.21829/myb.2018.2421443. Links
- García-Díaz, SE, Aldrete, A, Alvarado-Rosales, D, Cibrián-Tovar, D, Méndez-Montiel, JT, Valdovinos-Ponce, G, Equíhua-Martínez, A (2017). Efecto de Fusarium circinatum en la germinación y crecimiento de plántulas de Pinus greggii en tres sustratos. Agrociencia, 51(8), 895-908. https://www.researchgate.net/publication/328093696_Efecto_de_Fusarium_circinatum_en_la_germinacion_y_crecimiento_de_plantulas_de_Pinus_greggii_en_tres_sustratos. Links
- GeoEnciclopedia (2022). Tipos de climas en México. https://www.geoenciclopedia.com/tipos-de-climas-en-mexico-558.html (consulta, junio 2024). Links
- Hafizi, R, Salleh, B, Lattifah, Z (2013). Morphological and molecular characterization of Fusarium solani and F. oxysporum associated with crown disease of oil palm. Brazilian Journal of Microbiology, 44(3), 959-968. 10.1590/s1517-83822013000300047. Links
- Harčárová, M, Čonková, E, Proškovcová, M, Váczi, P, Marcinčáková, D, Bujňák, L (2021). Comparison of antifungal activity of selected essential oils against Fusarium graminearum in vitro. Annals of Agricultural and Environmental Medicine, 28(3), 414-418. 10.26444/aaem/137653. Links
- Kim, YJ, Kim, JH, Rho, JY (2019). Antifungal Activities of Streptomyces blastmyceticus Strain 12-6 Against Plant Pathogenic Fungi. Mycobiology, 47(3), 329-334. 10.1080/12298093.2019.1635425. Links
- Kiran, M, Gopakumar, S, Reshmy, R, Vidyasagaran, P (2021). Documentation and characterization of fungal diseases in nursery seedlings of teak (Tectona grandis L.f.) in Kerala, India. Indian Phytopathology, 74, 639-647. 10.1007/s42360-021-00333-3. Links
- Kisekka, R (2022). Major diseases of nursery forestry tree seedlings in Uganda. National Agricultural Research Organization, 1(1), 1-9. 10.13140/RG.2.2.28919.09125. Links
- Kowalska-Krochmal, B, Dudek-Wicher, R (2021). Inhibitory Concentration of Antibiotics: Methods, Interpretation, Clinical Relevance. Pathogens, 10, 1-21. 10.3390/pathogens10020165. Links
- Kumar, P, Mishra, S, Kumar, A, Kumar, SA (2016). Antifungal efficacy of plant essential oils against stored grain fungi of Fusarium spp.. Journal of Food Science and Technology, 53(10), 3725-3734. 10.1007/s13197-016-2347-0. Links
- Kumar, GP, Singh, SK, Shikha, S (2020). In vitro efficacy of different fungicides against Fusarium solani isolate causing root rot of papaya (Carica papaya L.). International Journal of Chemical Studies, 8(3), 221-224. 10.22271/chemi.2020.v8.i3c.9229. Links
- Kurt, S, Uysal, A, Soylu, EM, Kara, M, Soylu, S (2020). Characterization and pathogenicity of Fusarium solani associated with dry root rot of citrus in the eastern Mediterranean region of Turkey. Journal of General Plant Pathology, 86, 326-332. 10.1007/s10327-020-00922-6. Links
- Leslie, JF, Summerell, BA, Bulloc, S (2006). The Fusarium laboratory manual. First edition. Ed. Blackwell Publishing, Iowa, USA. 388p. 10.1002/9780470278376. Links
- Masiello, M, Somma, S, Ghiona, F, Francesco, LA, Moretti, A (2019). In Vitro and in Field Response of Different Fungicides against Aspergillus flavus and Fusarium Species Causing Ear Rot Disease of Maize. Toxins, 11(11), 1-18. 10.3390/toxins11010011. Links
- Medina-Osti, F, Gutiérrez-Díez, A, Ochoa-Ascencio, S, Sinagawa-García, SR (2022). In vitro sensitivity of Fusarium sacchari isolated from sugar cane to five fungicides. Mexican Journal of Phytopathology, 40(3), 447-457. 10.18781/R.MEX.FIT.2206-1. Links
- NCBI (National Center for Biotechnology Information) (2024). BLAST tool. https://blast.ncbi.nlm.nih.gov/Blast.cgi (consulta, junio 2024). Links
- Omar, NH, Mohd, M, Nik Mohd Izham, MN, Zakaria, L (2018). Characterization and pathogenicity of Fusarium species associated with leaf spot of mango (Mangifera indica L.). Microbial Pathogenesis, 114, 362-368. 10.1016/j.micpath.2017.12.026. Links
- Ortiz-Martínez, LE, Robles-Yerena, L, Leyva-Mir, SG, Camacho-Tapia, M, Juárez-Rodríguez, L (2022). Fusarium sp., causal agent of vascular wilt in citrus and its sensitivity to fungicides. Mexican Journal of Phytopathology, 40(1), 1-17. 10.18781/R.MEX.FIT.2106-3. Links
- Perczak, A, Gwiazdowska, D, Marchwinska, K, Jus, K, Gwiazdowski, R, Waskiewicz, A (2019). Antifungal activity of selected essential oils against Fusarium culmorum and F. graminearum and their secondary metabolites in wheat seeds. Archives of Microbiology, 201, 1085-1097. 10.1007/s00203-019-01673-5. Links
- Ríos-Hernández, TA, Uc-Várguez, A, Evangelista-Martínez, Z (2021). Control biológico de Fusarium oxysporum, agente causal de la pudrición del cormo en gladiolo, mediante estreptomicetos. Revista Mexicana de Fitopatología, 39(3), 391-413. 10.18781/R.MEX.FIT.2105-3. Links
- Secretaría de Medio Ambiente y Recursos Naturales (2017). Bosques tropicales, ecosistemas con gran riqueza de especies. https://www.gob.mx/semarnat/articulos/bosques-tropicales-ecosistemas-con-gran-riqueza-de-especies (consulta, junio 2024). Links
- Sabahi, F, Banihashemi, Z, Mirtalebi, M, Rep, M, Cacciola, SO (2023). Molecular Variability of the Fusarium solani Species Complex Associated with Fusarium Wilt of Melon in Iran. Journal of Fungi, 9(4), 1-19. 10.3390/jof9040486. Links
- Sharma, A, Rajendran, S, Srivastava, A, Sharma, S, Kundu, B (2016). Antifungal activities of selected essential oils against Fusarium oxysporum f. sp. lycopersici, with emphasis on Syzygium aromaticum essential oil. Journal of Bioscience and Bioengineering, 1(1), 1-6. 10.1016/j.jbiosc.2016.09.011. Links
- SNIGF (Sistema Nacional de Información y Gestión Forestal) (2021). Comisión Nacional Forestal. https://old-snigf.cnf.gob.mx/categoria-producto/noticias-del-sector-forestal/ (consulta enero 2021). Links
- Sun, HM, Ryu, H, Jong, JH, Hyo-Won, C (2023). Diversity and pathogenic characteristics of the Fusarium species isolated from minor legumes in Korea. Nature Portfolio, 13, 22516. 10.1038/s41598-023-49736-4. Links
- Uc-Várguez, A, López-Puc, G, Góngora-Canul, C, Martínez-Sebastián, M, Aguilera-Cauich, EA (2018). Spatio-temporal spread of foot rot (Lasiodiplodia theobromae) in Jatropha curcas L. plantations in Yucatán, México. European Journal of Plant Pathology, 150, 991-1000. 10.1007/s10658-017-1338-y. Links
- Vega-López, M, Granados-Montero, M (2023). Efficacy of benomyl and folpet on Fusarium oxysporum, a strawberry pathogen. Revista Mexicana de Ciencias Agrícolas, 14(3), 485-490. 10.29312/remexca.v14i3.3253. Links
- White, T, Bruns, T, Lee, S, Taylor, J (1990). Amplification phylogenetics. PCR Protocols: A guide to methods and applications. Innis, MA, Gelfand, DH, Sninsky, JJ, White, TJ. San Diego, California: Academic Press, 315-321. 10.1016/B978-0-12-372180-8.50042-1. Links
- Zárate-Ramos, A, Quero-Carrillo, AR, Miranda-Jiménez, L, Nava-Díaz, C, Robles-Yerena, L (2022). Fungicides and Bacillus subtilis against fungi isolated from commercial seed of side oats grama (Bouteloua curtipendula). Mexican Journal of Phytopathology, 40(1), 103-115. 10.18781/R.MEX.FIT.2104-4. Links